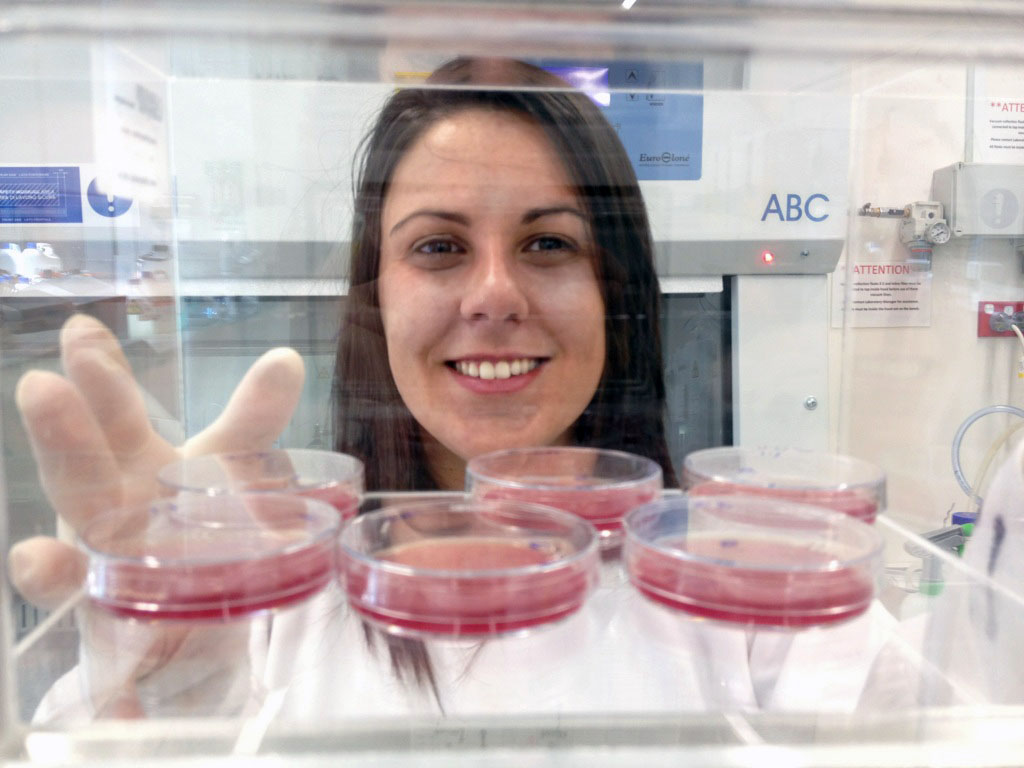
2 - Unnamed

Spotlight on the Centre for Molecular and Medical Research at Deakin University
27 July 2016
The Centre for Molecular and Medical Research (C-MMR) at Deakin University combines the leading medical and biomolecular research programs from the Faculty of Health and the Faculty of Science, Engineering and Built Environment, including those housed with our key partners, Barwon Health and CSIRO (AAHL). Collectively, the C-MMR comprises over 100 staff and research students and four distinct research facilities.
The research undertaken in the C-MMR is focused on the molecular basis of health and disease, spanning basic gene discovery and molecular analysis through to pre-clinical development, including translational research into novel strategies for optimising health and new therapeutic targets. The Infection and Immunity Theme is one of four research pillars in the C-MMR. C-MMR PhD Student Robert Sertori and researchers Dr Clifford Liongue and Dr Kat Matthews are pictured below (left to right).

The Infection and Immunity Theme investigates the biology of microbes and immune system development, including the interplay between the two at a molecular and cellular level. In particular, our research aims to understand the molecular basis of immune development, how the immune system utilises specific genes to suppress microbes, and how pathogens can penetrate and evade the immune defence from the host. Members of our theme work on a number of diseases that are critically important to human health, including infections with malaria, influenza, HIV-1, Hendra virus and Helicobacter, as well as allergy, asthma and immunodeficiency.The overarching goal of our research is to employ state of the art discovery-based approaches to identify new strategies to combat these diseases through improved prevention, surveillance and/or therapeutic approaches. Members of this Theme utilise extensive animal models (mouse, ferret, bat, chicken, zebrafish), supported by sophisticated genome engineering, high-resolution microscopy, molecular and bioinformatics approaches, as well as clinical studies.

